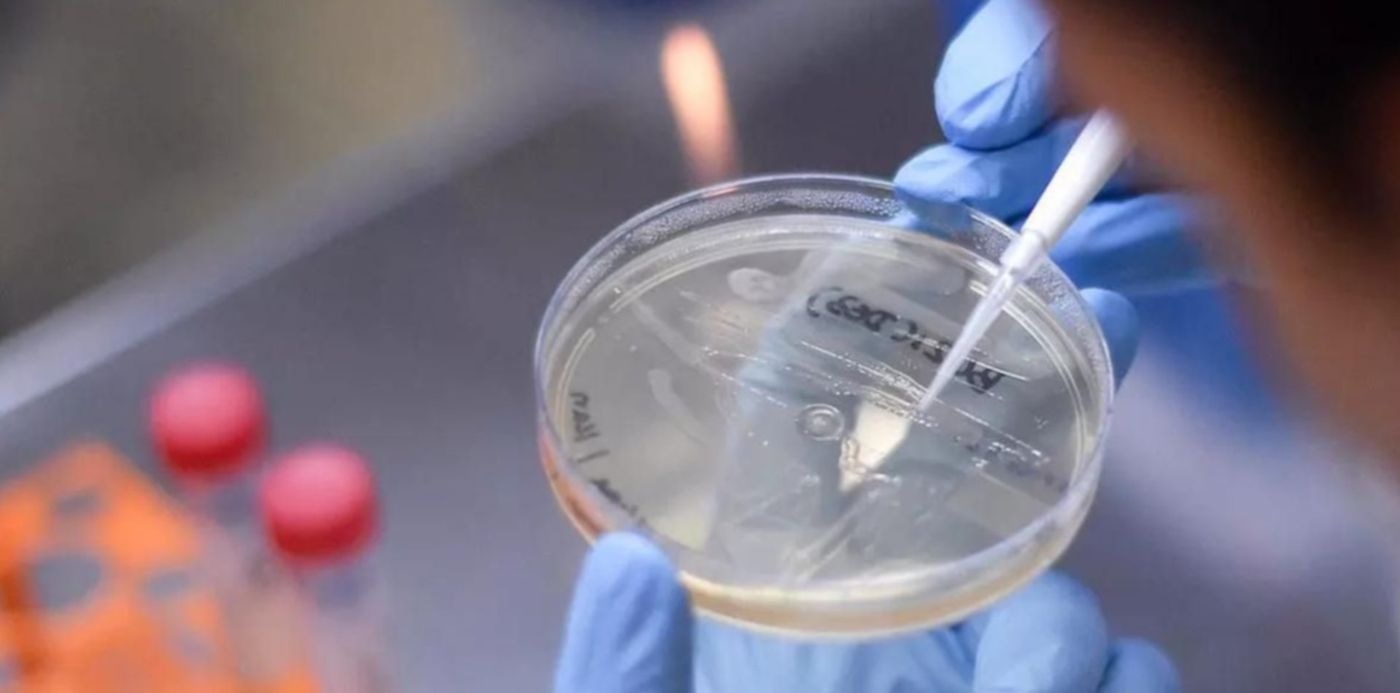
1624303272186.jpg?x=8&y=105&width=1179&height=590&rotate=0&scaleX=1&scaleY=1&ow=1200&oh=800&&cw=1920&ch=950

Mientras las restricciones son cada vez menos y los contagios y fallecidos por COVID-19 siguen descendiendo, crecen las dudas sobre si se dará una tercera ola en Argentina. En ese sentido, dos especialistas repasaron la situación epidemiológica del país, las variantes que circulan y explicaron qué factores se tienen que dar para evitar un nuevo brote de la enfermedad.
A pesar de que las variantes que tienen circulación comunitaria en Argentina son la Gamma (identificada por primera vez en Manaos) y la definida por la Organización Mundial de Salud (OMS) como Lambda (conocida como Andina), la que más preocupa a los expertos es la cepa Delta, que sería la que podría generar nuevos picos de infectados. Identificada por primera vez en la India en octubre del año pasado, la variante Delta impulsó de una nueva ola de coronavirus en varias partes del mundo debido a su mayor capacidad de contagio, y este viernes e conoció que hubo un brote de 43 casos en el Instituto ORT de Belgrano que sería por esta cepa.
En este marco, la viróloga Carolina Torres, integrante de Proyecto PAIS, y la bioquímica Josefina Campos, coordinadora de la Plataforma de Genómica y Bioinformática del ANLIS-Malbrán, indicaron todo lo que hay que saber sobre la cepa Delta en Argentina. Sobre los casos detectados, señalaron que si bien existen cadenas de transmisión local, todavía no se habla de circulación comunitaria porque éste es un concepto que define el Ministerio de Salud de la Nación teniendo en cuenta que definir "transmisión comunitaria" se requiere que exista a nivel de la comunidad un alto riesgo de contraer esta variante.
En esa línea, precisaron que las cadenas de transmisión aún pueden cortarse y que no necesariamente toda detección de caso sin nexo con viajero va a derivar en circulación comunitaria, sino que se trata de un estadio intermedio.

Asimismo, sostuvieron que la variante Delta se detectó hasta hoy en 142 países y un 90% de los nuevos casos secuenciados que se reportaban en julio en el mundo correspondía a esta variante y que en la mayoría de los lugares donde ingresó se convirtió rápidamente en predominante. A partir de que llegó a ser entre el 1 y el 5 por ciento de las detecciones, al mes superó el 50% y en seis a ocho semanas se convirtió en el 90% de los nuevos casos.
En Brasil, Perú, Paraguay, Colombia, Chile y Ecuador ya reportaron casos sin nexo con viajeros. Y en Brasil específicamente, donde se anunció circulación comunitaria en Río de Janeiro y San Pablo, ya la Delta representa el 60% de los nuevos casos reportados.

De esta manera, las especialistas remarcaron que lo que suceda con la Delta en nuestro país va a depender de múltiples factores como por ejemplo la interacción con las otras variante, la situación de la población respecto de la vacunación y cómo responde frente a las vacunas que hay en el país.
Por último, destacaron la importancia de avanzar con los esquemas completos de vacunación para lograr una mayor protección frente a esta variante y todas las variantes que puedan surgir, y así evitar a la tercera ola de COVID-19.